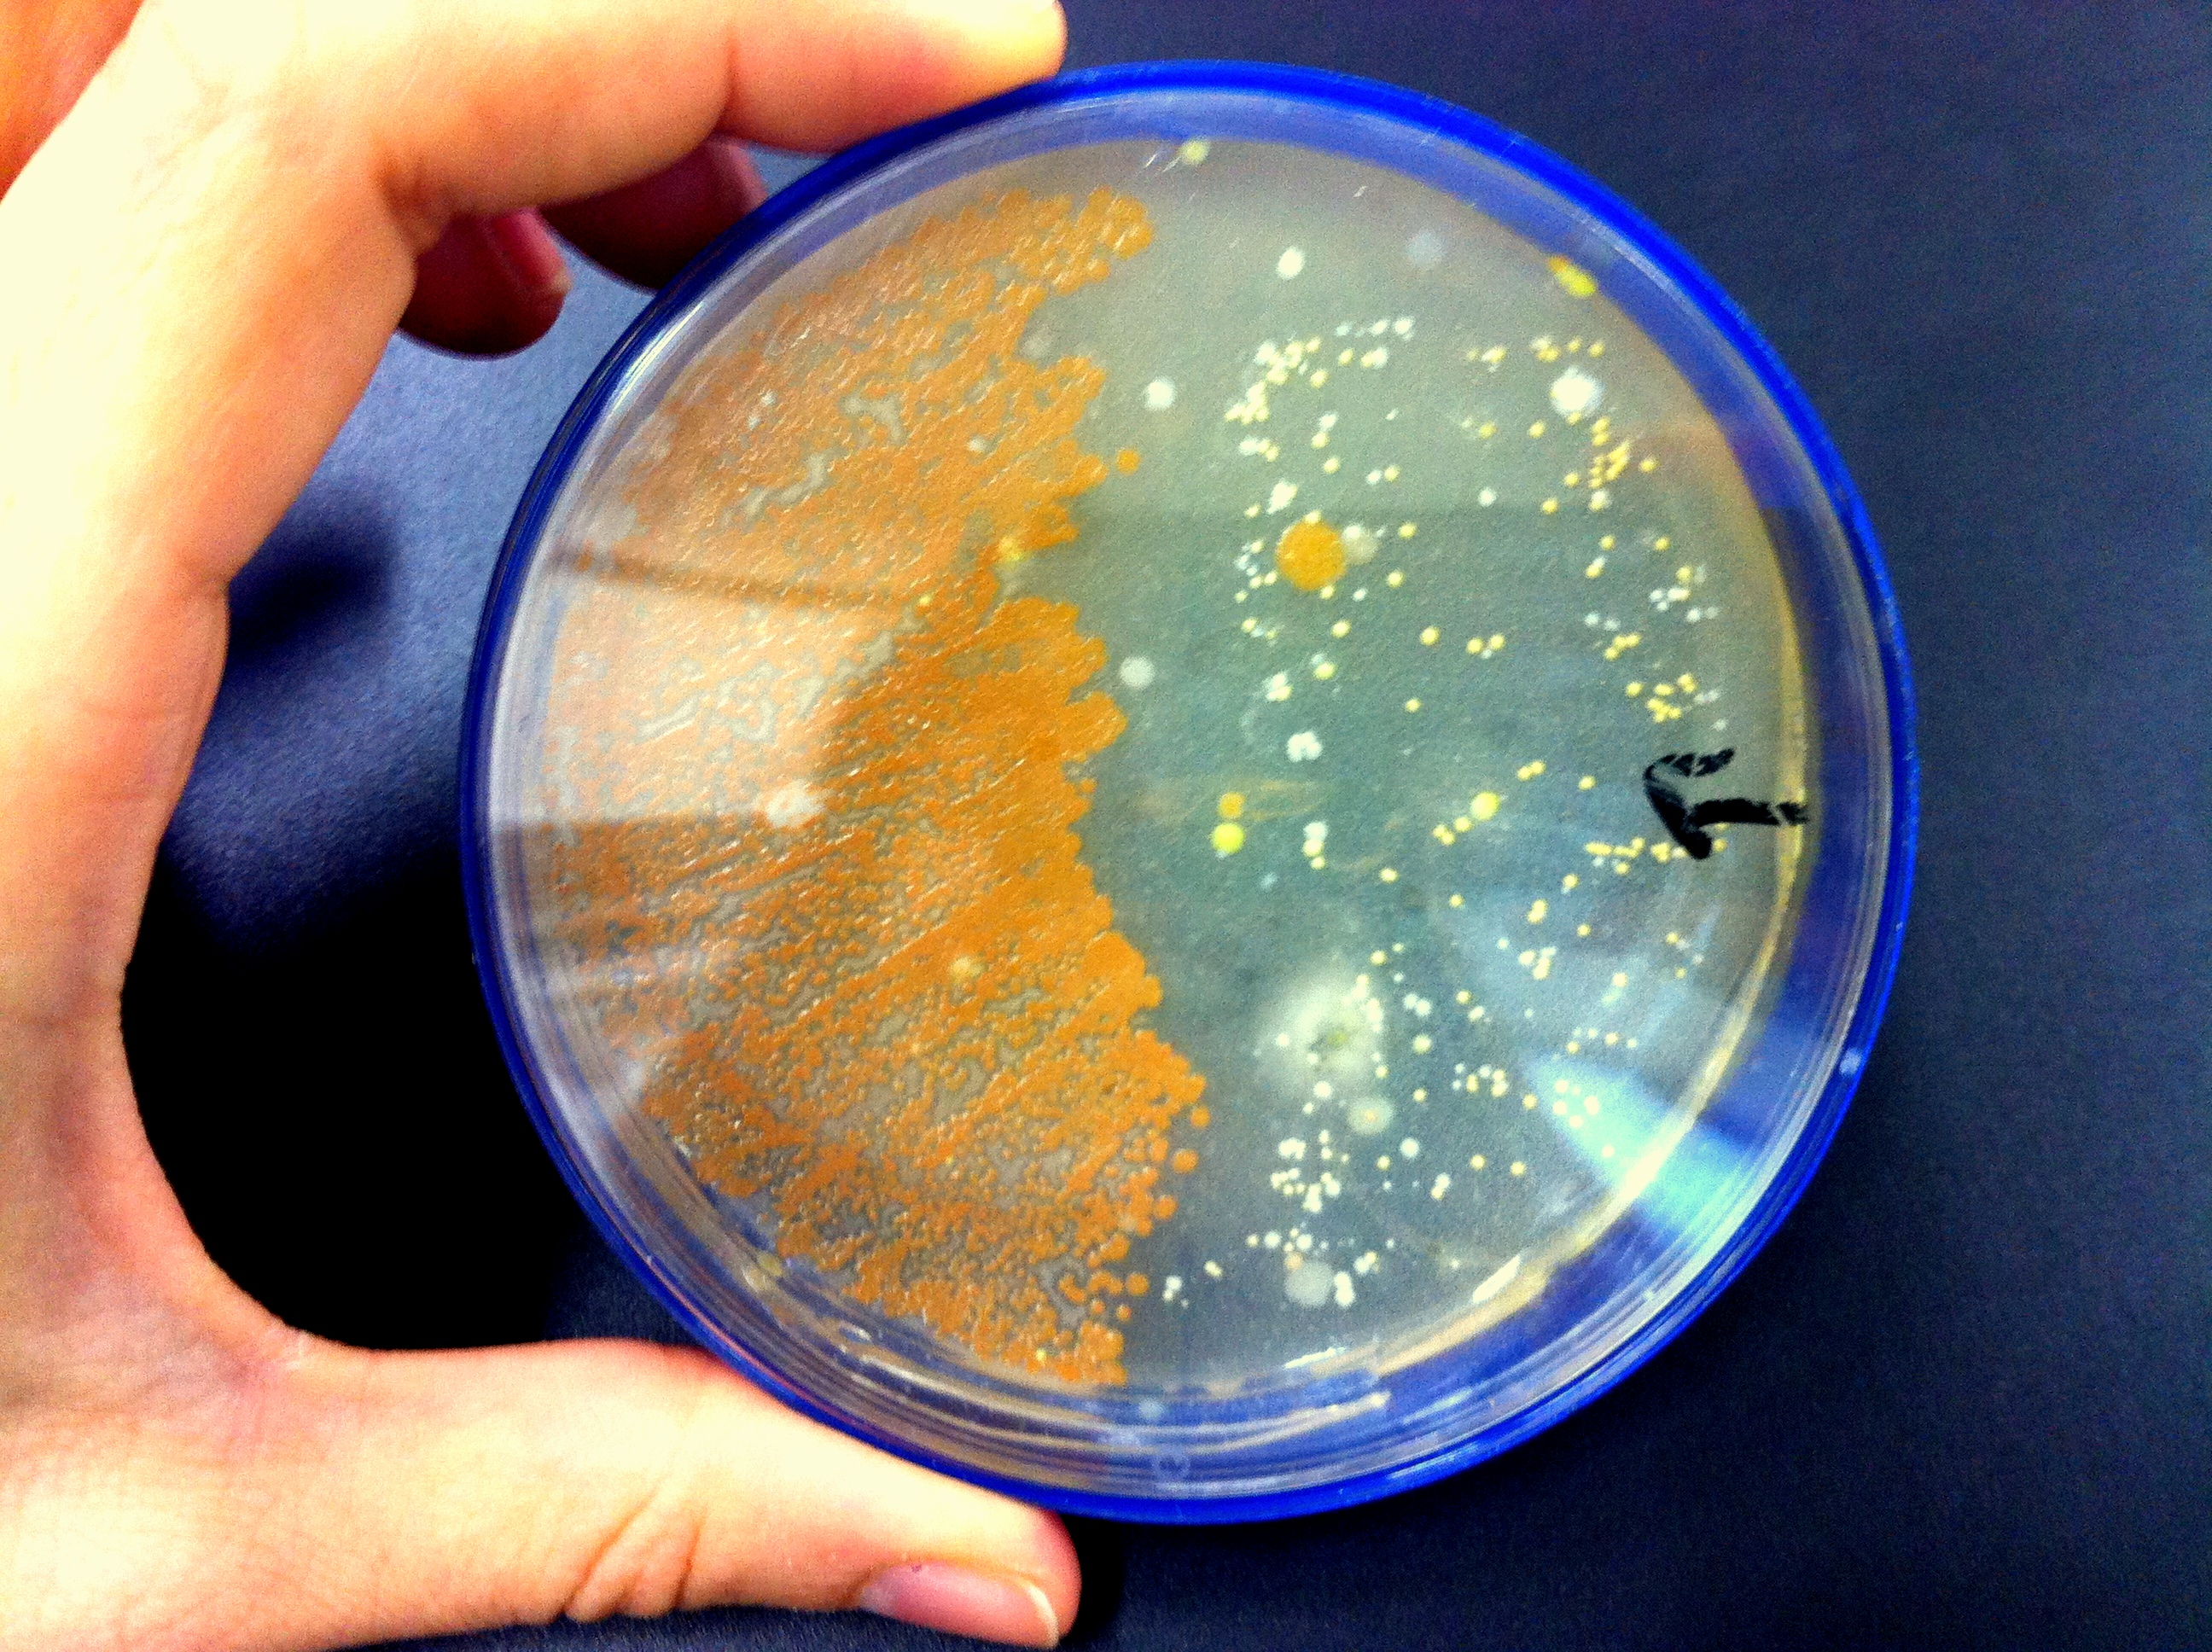
Una de las muestras estudiadas

¿Altera la música el crecimiento de las bacterias?, ¿puede un concierto de Mozart o las sugerentes voces de Aretha Franklin y Amy Winehouse producir un baby-boom bacteriano? Una profesora de ciencias planteó estas preguntas a un grupo de estudiantes de 3º de la ESO y aunque la primer reacción de una alumna fue: 'Bacterias, ¡qué asco!' ... todos se sintieron picados por el bichito de la curiosidad y se pusieron a trabajar para dar respuesta a estas enigmáticas cuestiones.
A Rebeca Sánchez le encanta enseñar y quiere contagiar su pasión por las ciencias a sus alumnos. Y eso que cuando decidió impulsar este proyecto necesitó que le 'prestaran' un centro educativo, dado que estaba en uno de los tantos intervalos de espera de la próxima sustitución en la bolsa de docentes. Mientras tanto, consideró que el curso Cómo motivar a los estudiantes mediante actividades científicas atractivas era una excelente oportunidad para aproximar a chicos y chicas de 3º de la ESO a la vida y obra de las bacterias. Le atraía el tema desde que leyó una noticia sobre cómo las bacterias 'trabajan' mejor en una depuradora de Alemania bajo efectos de la música clásica y una investigación realizada en la NASA sobre el efecto de las vibraciones en bacterias durante vuelos espaciales mostrando algunos resultados sorprendentes como, por ejemplo, el cambio en la resistencia a los antibióticos.
Como punto de partida buscó y halló en youtube un video sobre la noticia del tratamiento de aguas residuales en Alemania. Juan José Asensi, profesor del IES Sorolla donde llevaron a cabo el proyecto, realizó la transcripción antes de presentarlo a los chicos. No les sorprendió la percepción negativa que tenían de las bacterias, que suelen vincularlas -como la mayoría de la gente- a palabras como 'suciedad', 'enfermedad', 'riesgo', 'infección', 'basura' y 'repugnancia'. El pequeño video introductorio sirvió para hacerles conocer un 'buen servicio' de las bacterias, mostrando cómo trabajaban con ahínco en una depuradora transformada en un improvisado conciertazo de música clásica. Lo hacían tan bien que la empresa podía ahorrar en torno a los diez mil euros anuales gracias a la música. Quizás más de uno soñó con su maleta de bacterias emulando la manera de cultivar patatas de Matt Damon en un próximo viaje a Marte, sólo que al ritmo de raeggeton. Aunque flotaba la duda: ¿o es que acaso las bacterias tienen orejas?
Luego de un cuestionario inicial sobre el tema (las bacterias, esas desconocidas...), abordaron con entusiasmo las tareas: la selección de su música predilecta y la preparación de 'sus' muestras en las placas de Petri, sin olvidar el caldo de carne para 'alimentar' a las bacterias y el diseño del entorno apropiado para el experimento. Una muestra control fue colocada en un sitio silencioso mientras el resto se conectó a reproductores con auriculares a la música elegida en cada caso. Al cabo de una semana tenían que responder a las preguntas: ¿La música tiene un efecto en el tamaño o la cantidad de colonias de bacterias? ¿Tiene un determinado género musical un mayor efecto que otros? Los detalles sobre la marcha y resultados de este experimento pueden verse en la página web desarrollada.
Entre bromas sobre muestras de saliva y conjeturas sobre el gusto musical de las bacterias, términos como esterilización, antiséptico, asepsia y simbiosis pasaron a formar parte de su vocabulario habitual, a la vez que modificaban su visión sobre el universo bacteriano. El proyecto les permitió comprender algunos detalles de qué se hace en un laboratorio de microbiología, puesto que los profesores acudieron a la Universidad de Valencia para solicitar ayuda a los investigadores para analizar el crecimiento observado y profundizar en el tema.
A su vez leyeron artículos de divulgación científica, ampliando sus horizontes y debatiendo sobre el papel de las bacterias en la salud y la enfermedad, en la industria alimentaria, en los medicamentos y muchas otras funciones. Porque así son las bacterias ... las bacterias en tus zapatos delatan dónde has estado, cada familia tiene un aura bacteriana que deja su huella particular cuando se muda de casa, hay bacterias que pueden comer metales y hasta se puede pintar con ellas, como hace la artista María Peñil.
Los artículos que más les impactaron fueron sin lugar a dudas 'Tu caca cura ', sobre el transplante de heces y su efecto en el tratamiento de enfermedades y 'Niños nacidos por cesárea reciben bacterias vaginales de su madre ', sobre cómo al pasar una gasa conteniendo bacterias vaginales en el cuerpo del recién nacido se ayuda a compensar su microbiota para que sea similar a los nacidos por parto natural.
Sobre todo, los alumnos tomaron conciencia de que la conducta de las bacterias ante la música y las vibraciones, ya sea en la Tierra o más allá, tiene que ver con uno de los problemas más graves de la humanidad: el de las infecciones que son resistentes a los antibióticos. Y que los avances experimentados en nanomateriales pueden dar un nuevo giro a la búsqueda de soluciones, tal como lo muestra el artículo Sensors: good vibrations for bad bacteria.
Por si alguien tenía dudas, en la muestra control no se apreciaron los cambios operados en las restantes. A las bacterias les encanta la música, aunque no son amantes del rock and roll sino más bien de estilos clásicos.
Aggio, R.B.M; Obolonkin, V. and Villas-Boas, S. G. (2012). Sonic vibration affects the metabolism of yeast cells growing in liquid culture: a metabolomic study.Metabolomics 8:670–678.
(8 de junio de 2010). Civantos, D. Mozart acelera el trabajo de las bacterias en las plantas de aguas residuales
Juergensmeyer, E. A., & Juergensmeyer, M. A. (2004). Effect of vibration on bacterial growth and antibiotic resistance. NASA Grant NAG2-1512, May 2001-October 2004.
Leys, N. M. E. J., Hendrickx, L., De Boever, P., Baatout, S., & Mergeay, M. (2004). Space flight effects on bacterial physiology. Journal of biological regulators and homeostatic agents, 18(2), 193-199.
McKendry, R. A. & Kappeler, N. (2013). Sensors: Good vibrations for bad bacteria. Nature Nanotechnology 8, 483-484.doi:10.1038/nnano.2013.127
Sarvaiya, N., & Kothari, V. (2015). Effect of audible sound in form of music on microbial growth and production of certain important metabolites. Microbiology,84(2), 227-235.